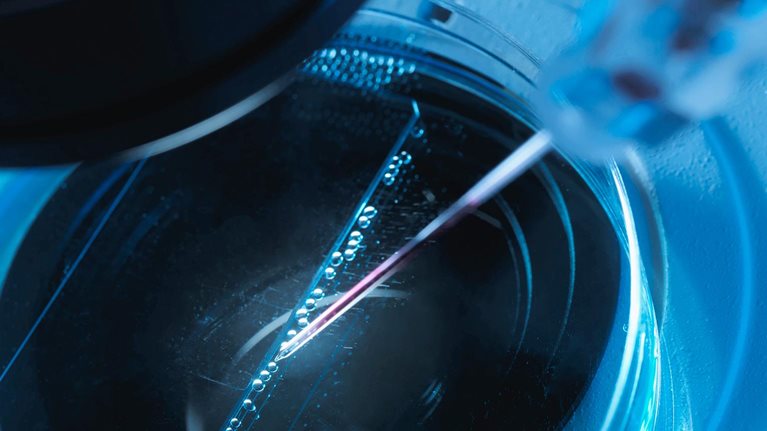
Can European biotechs achieve greater scale in a fragmented landscape?

European biotechs have established a position of strength from which to enter the industry’s next act. Over the past three years, Europe’s biotech industry has made meaningful progress on attracting capital and bringing products to market.
Europe’s complex biotech landscape comprises hundreds of companies, dozens of countries, and multiple paths to innovation and financing. We mapped out 1,382 biotechs based in Europe and nine clusters emerged. As in previous years, service providers remain the largest cluster, with 29 percent of the European landscape.
While innovation is strong, it varies by country. France, Germany, and the United Kingdom (home to the largest biotech hub) stand out as the top three biotech centers in Europe, and together account for half of all European biotechs. France, Switzerland, and the United Kingdom have seen the fastest growth, accounting for 63 percent of the biotechs founded between 2018 and 2020. Other European countries are maintaining a steady pace, such as Germany; however, a few are losing momentum.
New therapeutic modalities are gaining traction. Our research shows that 51 percent of European biotechs founded after 2015 are focused on cell and gene therapies, immunotherapies, and antibodies. European biotechs have also been focusing more on specific therapeutic areas rather than multiple or nonspecific therapeutics areas.
Read more in our article “Can European biotechs achieve greater scale in a fragmented landscape?” and download our full report.